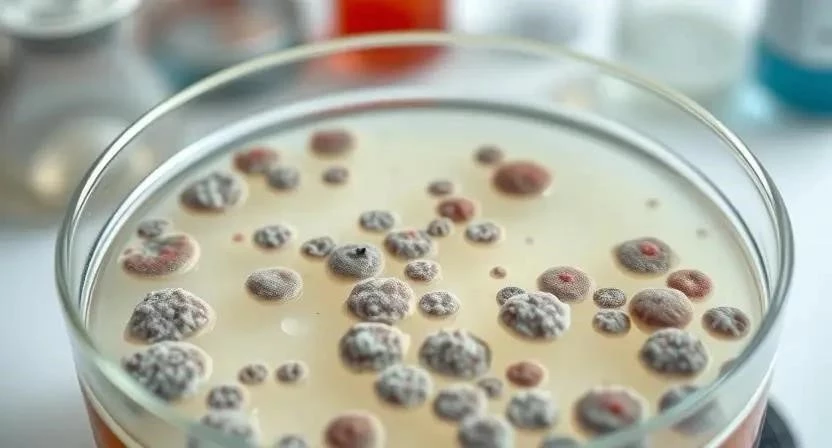

Задумывались ли вы, как перенесенная вирусная инфекция может повлиять на гормональный фон? Оказывается, связь между вирусами и эндокринной системой гораздо теснее, чем кажется. По статистике, у значительного процента пациентов, перенесших вирусные заболевания, наблюдаются те или иные эндокринные нарушения. В этой статье мы подробно рассмотрим, как вирусные инфекции влияют на эндокринную систему, какие симптомы могут указывать на проблемы, и какие методы лечения существуют. Ключевое слово – вирусные инфекции эндокринная система.
- Вирусные инфекции и эндокринная система: Механизмы влияния, как вирусы воздействуют на эндокринные железы
- Эндокринные нарушения после вирусных инфекций: Обзор наиболее распространенных нарушений
- Гипотиреоз: Симптомы, диагностика, лечение после вирусной инфекции
- Гипоталамический синдром: Причины, проявления, терапия
- Мальнутриция: Связь с вирусными инфекциями, восстановление питания
- Диабетическая фетопатия: Влияние вирусных инфекций на беременность и развитие плода
- Эндокринное бесплодие: Причины, диагностика, методы лечения
- Эндокринные карциномы (карциноиды): Связь с вирусными инфекциями, диагностика и лечение
- Множественные эндокринные неоплазии (МЭН): Наследственность и вирусные факторы
- Субфебрильная температура: Связь с вирусными инфекциями и эндокринными нарушениями
- Профилактика эндокринных нарушений после вирусных инфекций: Укрепление иммунитета, здоровый образ жизни
- FAQ: Ответы на часто задаваемые вопросы
- Таблица 1: Симптомы и признаки различных эндокринных нарушений после вирусных инфекций
- Таблица 2: Методы диагностики эндокринных нарушений
- Таблица 3: Схема лечения различных эндокринных нарушений
Вирусные инфекции и эндокринная система: Механизмы влияния, как вирусы воздействуют на эндокринные железы
Вирусы способны оказывать прямое воздействие на эндокринные железы, проникая в клетки и нарушая их нормальную функцию. Некоторые вирусы могут вызывать аутоиммунные реакции, при которых иммунная система начинает атаковать собственные ткани эндокринных желез. Кроме того, вирусные инфекции могут приводить к воспалению и повреждению эндокринных органов, что также нарушает их гормональную функцию. Я сам столкнулся с тем, что после гриппа у меня значительно снизился уровень тестостерона, что потребовало длительного восстановления.
Эндокринные нарушения после вирусных инфекций: Обзор наиболее распространенных нарушений
После перенесенных вирусных инфекций могут развиться различные эндокринные нарушения. Среди наиболее распространенных – гипотиреоз (снижение функции щитовидной железы), гипоталамический синдром (нарушение работы гипоталамуса), развитие или обострение сахарного диабета, а также эндокринное бесплодие. Важно понимать, что эти нарушения могут проявляться не сразу, а спустя некоторое время после перенесенной инфекции. Один из моих знакомых долгое время не мог зачать ребенка после перенесенного COVID-19, и только после обследования выяснилось, что у него развился эндокринный фактор бесплодия.
Гипотиреоз: Симптомы, диагностика, лечение после вирусной инфекции
Гипотиреоз, развившийся после вирусной инфекции, может проявляться слабостью, утомляемостью, набором веса, сухостью кожи, выпадением волос и ухудшением памяти. Диагностика включает анализ крови на гормоны щитовидной железы (ТТГ, Т4 свободный). Лечение заключается в заместительной терапии гормонами щитовидной железы. Я помню, как моя бабушка после тяжелой простуды стала чувствовать постоянную усталость и сонливость. Оказалось, что у нее развился гипотиреоз, который успешно скорректировали гормональной терапией.
Гипоталамический синдром: Причины, проявления, терапия
Гипоталамический синдром возникает из-за нарушения работы гипоталамуса, который регулирует многие функции организма, включая гормональный баланс. Симптомы могут быть разнообразными: нарушение сна, аппетита, терморегуляции, артериального давления, эмоциональная лабильность. Терапия направлена на восстановление нормальной работы гипоталамуса и коррекцию гормональных нарушений.
Мальнутриция: Связь с вирусными инфекциями, восстановление питания
Вирусные инфекции могут приводить к мальнутриции (недостаточному питанию) из-за снижения аппетита, нарушения всасывания питательных веществ и повышенной потребности организма в энергии. Восстановление питания включает сбалансированную диету, богатую белками, витаминами и минералами. Я всегда советую своим пациентам после перенесенных инфекций уделять особое внимание питанию, чтобы быстрее восстановить силы.
Диабетическая фетопатия: Влияние вирусных инфекций на беременность и развитие плода
Вирусные инфекции во время беременности могут повышать риск развития диабетической фетопатии – состояния, при котором у матери развивается сахарный диабет, а плод страдает от недостатка кислорода и питательных веществ. Важно контролировать уровень сахара в крови и соблюдать рекомендации врача.
Эндокринное бесплодие: Причины, диагностика, методы лечения
Эндокринное бесплодие может быть вызвано нарушениями в работе гипоталамуса, гипофиза, щитовидной железы, надпочечников или яичников. Диагностика включает анализ гормонального фона и проведение различных исследований. Методы лечения включают гормональную терапию, хирургическое вмешательство и вспомогательные репродуктивные технологии.

Эндокринные карциномы (карциноиды): Связь с вирусными инфекциями, диагностика и лечение
Некоторые вирусные инфекции могут повышать риск развития эндокринных карцином, таких как карциноиды. Диагностика включает проведение биопсии и различных визуализационных исследований. Лечение зависит от типа и стадии карциномы.
Множественные эндокринные неоплазии (МЭН): Наследственность и вирусные факторы
Множественные эндокринные неоплазии (МЭН) – это генетические заболевания, при которых в организме развиваются опухоли нескольких эндокринных желез. Вирусные факторы могут играть роль в развитии МЭН у людей с генетической предрасположенностью.
Субфебрильная температура: Связь с вирусными инфекциями и эндокринными нарушениями
Субфебрильная температура (37-38°C) может быть одним из признаков вирусной инфекции или эндокринного нарушения, например, гипотиреоза. Важно выяснить причину субфебрильной температуры и провести соответствующее лечение.
Профилактика эндокринных нарушений после вирусных инфекций: Укрепление иммунитета, здоровый образ жизни
Профилактика эндокринных нарушений после вирусных инфекций включает укрепление иммунитета, здоровый образ жизни, сбалансированное питание, регулярные физические упражнения и избегание стрессов. Я всегда говорю своим пациентам, что здоровый образ жизни – это лучшая профилактика любых заболеваний, в том числе и эндокринных.
FAQ: Ответы на часто задаваемые вопросы
Вопрос: Какие анализы нужно сдать, чтобы проверить работу эндокринной системы после вирусной инфекции?
Ответ: Необходимо сдать анализы на гормоны щитовидной железы (ТТГ, Т4 свободный), гормоны гипофиза, кортизол, глюкозу, инсулин и другие гормоны по назначению врача.
Вопрос: Как долго может длиться восстановление эндокринной системы после вирусной инфекции?
Ответ: Срок восстановления зависит от тяжести инфекции и степени поражения эндокринных желез. В некоторых случаях восстановление может занять несколько месяцев или даже лет.
Вопрос: Какие препараты используются для лечения эндокринных нарушений после вирусных инфекций?
Ответ: Препараты зависят от типа нарушения. Могут использоваться гормональные препараты, витамины, минералы и другие лекарства.
Таблица 1: Симптомы и признаки различных эндокринных нарушений после вирусных инфекций
| Нарушение | Симптомы |
|---|---|
| Гипотиреоз | Усталость, набор веса, сухость кожи, выпадение волос, запоры |
| Гипоталамический синдром | Нарушение сна, аппетита, терморегуляции, эмоциональная лабильность |
| Сахарный диабет | Жажда, частое мочеиспускание, слабость, потеря веса |
| Эндокринное бесплодие | Нарушение менструального цикла, отсутствие овуляции, невозможность забеременеть |
| Гиперкортицизм | Набор веса, лунообразное лицо, повышенное артериальное давление |
Таблица 2: Методы диагностики эндокринных нарушений
| Метод | Описание |
|---|---|
| Анализ крови на гормоны | Определение уровня гормонов в крови |
| УЗИ щитовидной железы | Оценка структуры и размеров щитовидной железы |
| КТ или МРТ гипофиза | Визуализация гипофиза для выявления опухолей |
| Глюкозотолерантный тест | Оценка способности организма усваивать глюкозу |
| Биопсия | Взятие образца ткани для исследования |
Таблица 3: Схема лечения различных эндокринных нарушений
| Нарушение | Лечение |
|---|---|
| Гипотиреоз | Заместительная терапия гормонами щитовидной железы |
| Гипоталамический синдром | Гормональная терапия, психотерапия |
| Сахарный диабет | Диета, физические упражнения, лекарственные препараты |
| Эндокринное бесплодие | Гормональная терапия, вспомогательные репродуктивные технологии |
| Гиперкортицизм | Хирургическое удаление опухоли, лекарственная терапия |
